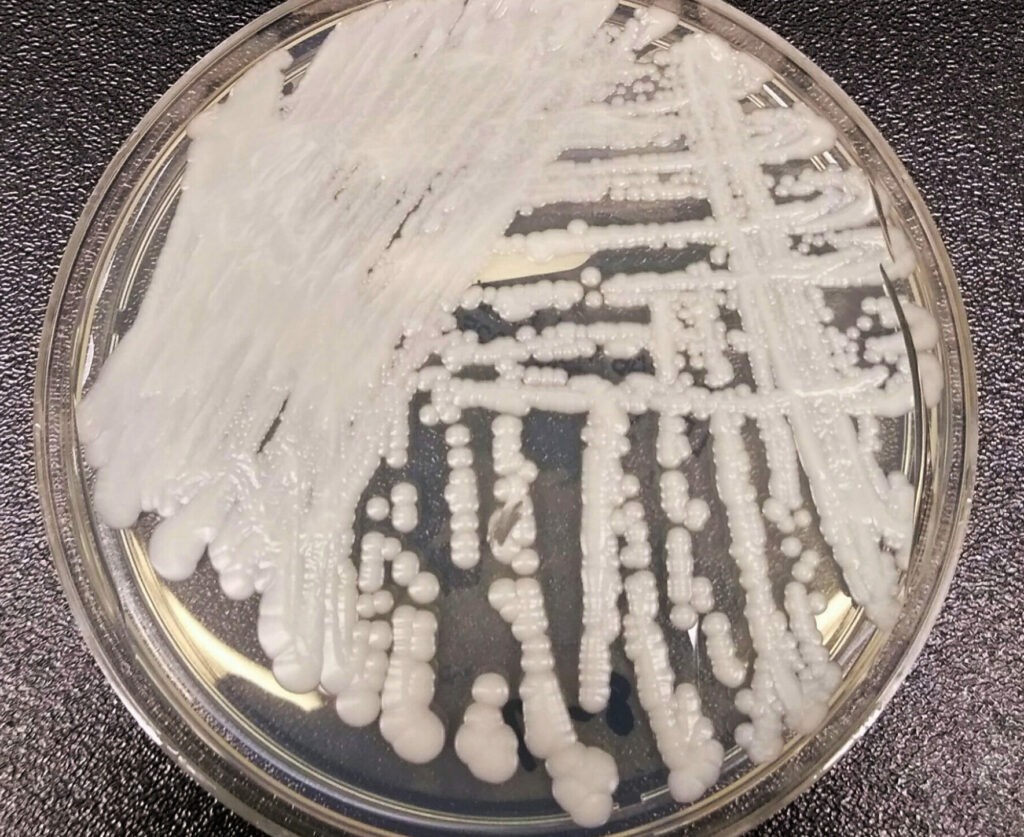
Belgian residents obliged to report rising 'super-fungus'

The increase in cases of the ‘super-fungus’ Candida auris has continued globally, with Belgium reporting 14 instances since 2016, six of which were recorded in 2023 alone.
Belgian health authorities are poised to make it mandatory to report all infections of this fungus, according to a weekend report by Het Niewsblad and Professor Katrien Lagrou of KULeuven University.
First identified in Japan in 2009, Candida auris rose to prominence in 2022 when it was designated a top-priority fungus by the World Health Organisation. There has been a surge in cases worldwide in recent years.
Germany reported 77 cases last year, a sixfold increase from the previous years. Belgium has also seen an uptick, with six of the 14 cases reported since 2016 occurring in 2023, according to Sciensano data.
What distinguishes the current situation from the past is that the cases were previously "imported", whereas recently at least three were not linked to hospital stays abroad. "This indicates that the disease is present and likely to occur more frequently," explains Professor Lagrou.
Candida auris is highly resistant to most treatments and can cause a deadly disease known as candidiasis. Although most people carrying the fungus do not develop symptoms, individuals with weakened immune systems are particularly at risk of severe infection.